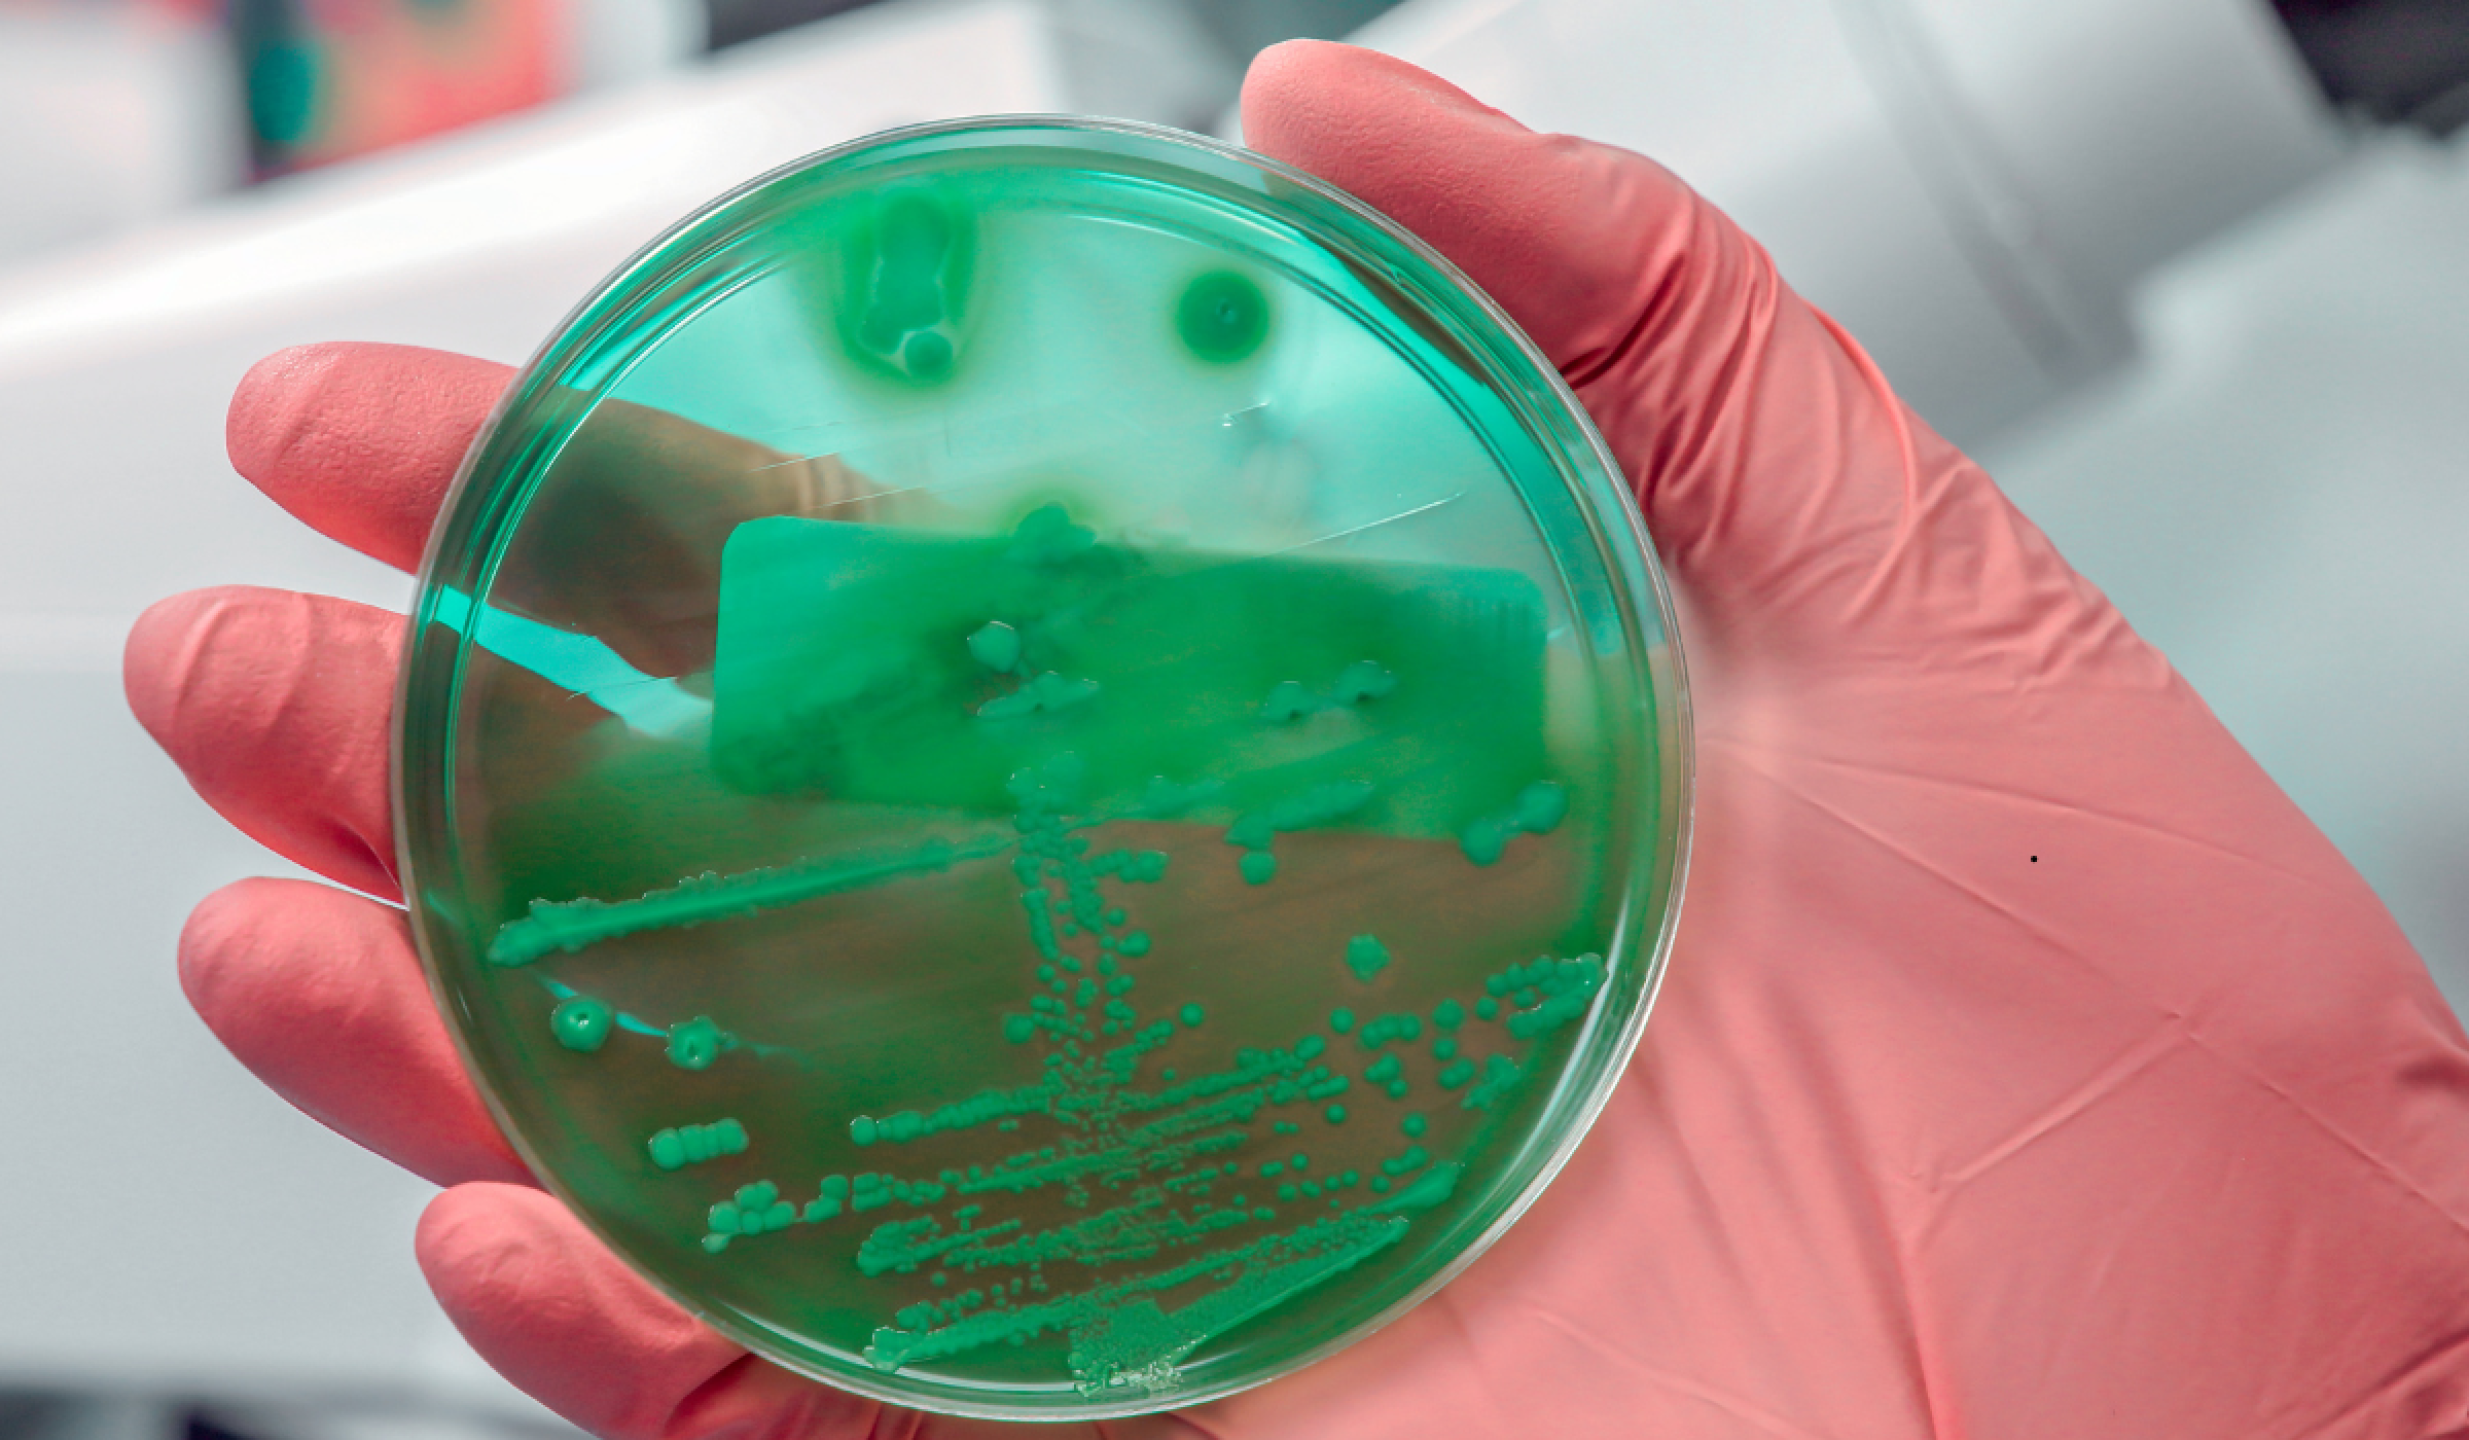

Bacteria Klebsiella oxytoca: estas son las acciones que ha implementado la Cofepris ante brote
La Comisión Federal para la Protección contra Riesgos Sanitarios (Cofepris) ha emitido una alerta sanitaria a raíz del brote de la bacteria Klebsiella oxytoca

OAXACA DE JUÁREZ, OAXACA, 14MARZO2024.- Este jueves trabajadores del hospital civil Doctor Aurelio Valdivieso ubicado en la capital de Oaxaca, denunciaron el fallo de elevadores en la institución, que desde el fin de semana dejaron de funcionar, además de saturación en los servicios de urgencias y hospitalización. Diariamente camilleros e incluso familiares de internos han subido de 15 a 20 pacientes al 2º, 3º y 4º piso. Al centro médico que cuenta con 108 camas censables, arriban diariamente pacientes de las 8 regiones del estado. Los trabajadores exigen a las autoridades atender la problemática que representa un riesgo para usuarios y personal. FOTO: CAROLINA JIMÉNEZ/CUARTOSCURO.COM
/Foto: Cuartoscuro Carolina Jiménez Mariscal
La Comisión Federal para la Protección contra Riesgos Sanitarios (Cofepris) ha emitido una alerta sanitaria a raíz del brote de la bacteria Klebsiella oxytoca, detectado en varias unidades de atención del Estado de México. Este brote está vinculado a una posible contaminación de Nutrición Parenteral (NPT) o de los insumos utilizados para su administración.
Hasta la fecha, se han identificado 20 casos relacionados con este brote, de los cuales 13 pacientes han fallecido. Las autoridades están investigando si estos decesos están directamente vinculados con la infección por la bacteria. En cuanto a los 7 pacientes restantes, se encuentran recibiendo atención médica, y sus cultivos de bacterias resultaron negativos tras el tratamiento.
>>> ES DE INTERÉS: “Bajo control” los casos de Klebsiella oxytoca: Salud Edomex
Desde el 29 de noviembre, Cofepris ha tomado medidas para controlar la propagación de este brote, manteniendo un monitoreo constante en las unidades de salud y realizando análisis exhaustivos para identificar el origen de la infección.
Acciones de Cofepris y Otras Autoridades
La Cofepris, al identificar que el brote podría estar relacionado con la contaminación de nutrición parenteral, procedió a la inmovilización preventiva de los lotes de soluciones intravenosas producidos por una empresa del Estado de México desde el 21 de noviembre de 2024. Esta acción se mantendrá hasta obtener resultados definitivos tras analizar las materias primas utilizadas.
Además, la Cofepris llevó a cabo una inspección en las instalaciones de la central de mezclas donde se produjeron las soluciones paraenterales. Los resultados de la inspección no revelaron hallazgos críticos, pero se sigue investigando para asegurar la seguridad de los productos involucrados.
>>> LEE TAMBIÉN: Eje Centra | lSheinbaum anuncia acciones por brote bacteriano de Klebsiella oxytoca en Edomex
Por otro lado, el Instituto de Diagnóstico y Referencia Epidemiológica (InDRE) ha aislado muestras de la bacteria tanto de las muestras humanas como de los cultivos de las soluciones paraenterales, lo que permitirá avanzar en la identificación de la fuente exacta del brote.
Klebsiella oxytoca es una bacteria gram-negativa que comúnmente habita en el tracto gastrointestinal de humanos y animales. Esta bacteria puede causar infecciones, especialmente en individuos con sistemas inmunitarios debilitados. Además, Klebsiella oxytoca se desarrolla en presencia de oxígeno y puede estar presente en el medio ambiente.
La Secretaría de Salud, la Dirección General de Epidemiología, el InDRE, y la Cofepris, junto con las autoridades sanitarias del Estado de México, trabajan de manera conjunta para esclarecer el origen de este brote. A medida que avancen las investigaciones, se continuará informando sobre cualquier novedad o avance en la situación. DJ
🚨#CofeprisAlerta🚨
— COFEPRIS (@COFEPRIS) December 7, 2024
Sobre inmovilización de soluciones intravenosas de nutrición parenteral (NTP) preparadas.
👉https://t.co/O7YI0BslYK
Nota informativa SSA: https://t.co/K9HbjfRu8s pic.twitter.com/E3bYYnZylB